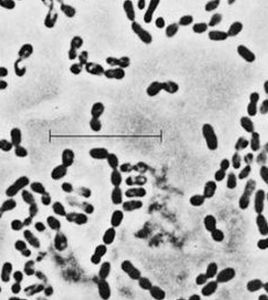
明串珠菌二糖

詞性解釋
中文翻譯[HELP]明串珠菌二糖,吡喃果糖-5-葡糖苷
明串珠菌二糖是一種化學品,主要作用為細菌的抑制效果。別名明串珠菌二糖,吡喃果糖-5-葡糖苷。
Langmjolk等。三、明串珠菌屬與其他的乳酸菌相比,明串珠菌是獨特的,屬於乳酸異型發酵的嗜溫型球菌。明串珠菌細胞呈球形,尤其是生長在瓊脂培養基上時...。明串珠菌不能水解精氨酸,需要不同的B族維生素才能生長。套用於乳品生產的明...
發酵劑菌種分類 菌種的選擇 發酵劑菌種的分離、鑑別與活化有機酸、醇、二氧化碳、氫等。在食品中使用的菌種有葡聚糖明串珠菌和乳脂明...主要作用的一類菌。按其對糖發酵特性可分為同型發酵菌和異型發酵菌。同型發酵...、乳酸乳桿菌、乳鏈球菌、嗜熱鏈球菌及乳鏈球菌丁二酮乳新亞種。異型發酵菌...
食品分類 細菌介紹 用於發酵細菌 發酵劑 酵母菌色素家族添加了更多的色彩。黃酮類化合物在植物體內大部分與糖結合成苷,一部分以游離形式存在。在高等植物體中常以游離態或與糖成苷的形式存在,在花、葉...,黃酮類、黃酮醇類、二氫黃酮類、二氫黃酮醇類、異黃酮類、二氫異黃酮類、查耳酮...
植物源有效成分 產物相冊類目 微生物及其發酵液有效成分 海洋天然產物有效成分食品,占優勢的微生物菌群是嗜溫性的乳酸鏈球菌和明串珠菌,通常生長在10一... diacetylactis)、腸膜明串珠菌乳脂亞種和腸膜明串珠茵(Leuconostoc...酸牛乳、活性乳、以及乾酪、酸性奶油等。含有大量有益活性菌的發酵乳更是營養...
簡介 歷史 類型 功能特性 區分的乳酸鏈球菌和明串珠菌,通常生長在10一40℃的溫度範圍內,最佳生長溫度... ssp.lactis var.diacetylactis)、腸膜明串珠菌乳脂亞種和腸膜明串珠茵( Leuconostoc mesenteroides ssp....
斯堪的納維亞酪乳詳細說明 發酵乳定義及種類桿菌屬、明串珠菌屬、片球菌屬、鏈球菌屬。另外,根霉屬、毛霉屬、芽枝霉屬...的生產菌主要有根霉和毛霉,尤其米根霉產酸力強,發酵糖質原料時,對糖...二酸短桿菌發酵液體石蠟生產α-酮戊二酸,用銅綠色假單孢菌以萘為碳源生產...
有機酸發酵微生物 正文 配圖 相關連線莢果,通常分為大中小三種,形狀有蠶繭形,串珠形和曲棍形。蠶繭形的莢果多具有種子2粒,串珠形和曲棍形的莢果,一般都具有種子3粒以上。果殼的顏色多為...25g,菌粉加清水100~150ml調成菌液,均勻地拌在種子上。 整地與施肥...
。盲腸之盲袋可見二三條連結成V或Y形的黏膜皺襞,是確認盲腸的重要標記。在其...
生理要點 消化道免疫 胃腸激素 進展 研究方向